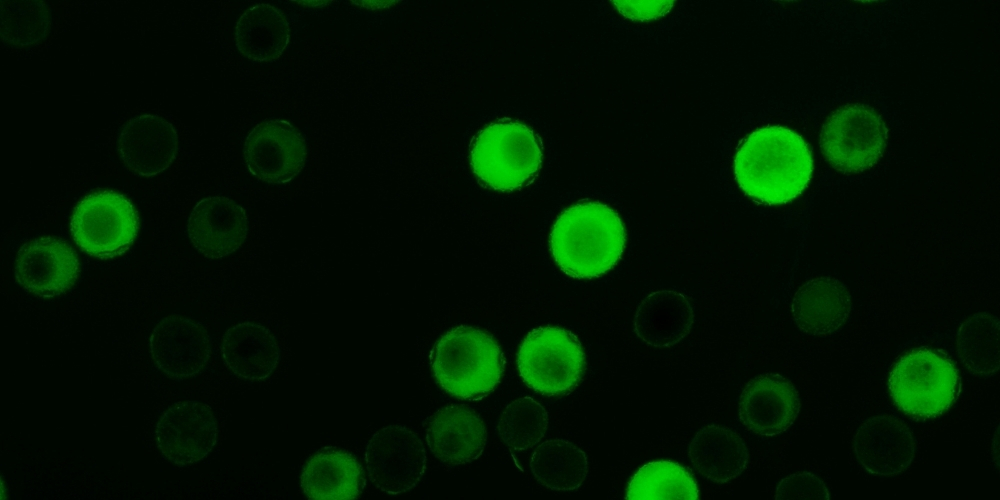

Nuestras soluciones
Evaluación de la diversidad vegetal
Si necesitas estudiar tu diversidad, podemos ayudarte mediante análisis por marcadores moleculares, medida de ploidía, análisis de viabilidad de polen, caracterización masiva o asistencia en la caracterización.

Marcadores Moleculares
Nos permiten conocer características de nuestras plantas sin tener que hacer un gran esfuerzo de análisis en campo. Podemos saber, por ejemplo, las resistencias frente a enfermedades que tienen nuestras plantas sin que las plantas se vean afectadas por la enfermedad. Además, nos permite conocer la distancia genética que hay entre dos individuos o el grado de heterocigosidad.

Medida de la ploidía
Mediante citometría es una técnica analítica que puede ser muy relevante en un proceso de mejora genética. De hecho, esta técnica es necesaria para la producción de poliploides o la producción de frutos sin semilla.
Análisis de viabilidad del polen
Hacer esto puede arrojar información acerca de la vida útil de polen y el tiempo máximo de almacenado. Esto es útil en caso de tener que realizar polinizaciones entre plantas.

Caracterización de planta y fruto
Es una etapa esencial en un programa de mejora genética vegetal, ya que la correcta evaluación de la diversidad es lo que nos permite, junto con los marcadores moleculares, seleccionar los mejores individuos en etapas posteriores. Disponemos de diversas plataformas y softwares de análisis de imagen y organización de datos que facilitan y optimizan la caracterización de planta y fruto.

